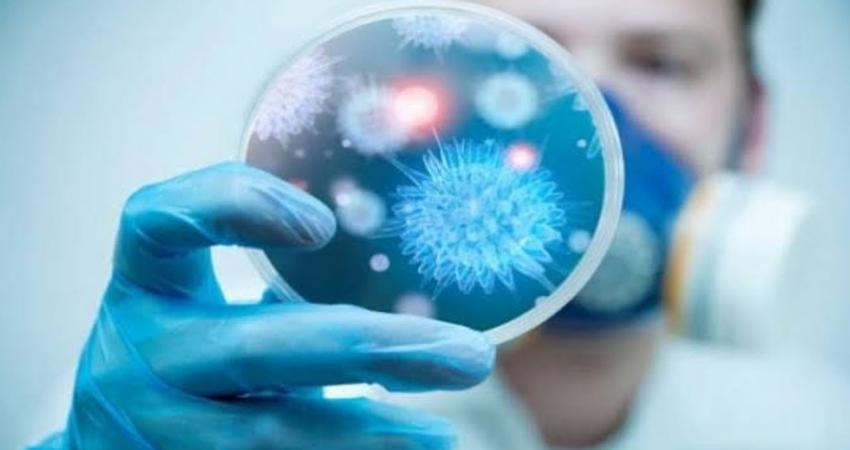

كشف مستشار وزير الصحة والسكان لشئون الإعلام والمتحدث الرسمي للوزارة د.خالد مجاهد، حقيقة المعلومات المتداولة على بعض صفحات مواقع التواصل الاجتماعي بشأن سبب زيارة وزيرة الصحة والسكان د.هالة زايد، لدولة الصين.
ونفى «مجاهد» ما تم تداوله بأن الغرض من الزيارة الكشف عن مصل مصري للوقاية من فيروس كورونا المستجد، مؤكدا أن هذه المعلومات لا أساس لها من الصحة.
وأكد مجاهد أن زيارة الوزيرة بتكليف من الرئيس عبدالفتاح السيسي، حاملة هدية مصر للشعب الصيني من المستلزمات الطبية، مع رسالة تضامن من مصر مع الشعب الصيني لمواجهة فيروس الكورونا.
وكانت مواقع التواصل الاجتماعي، نشرت ان الهدف من زيارة وزيرة الصحة الي الصين، للكشف عن مصل مصري للوقايه من فيروس كورونا المستجد.
وأكدت وزارة الصحة والسكان أن الدكتورة هالة زايد وزيرة الصحة والسكان والوفد المرافق لها سيخضع للفحص الطبي والمتابعة الدورية على مدار 14 يوما فترة حضانة المرض بعد العودة من الصين.
قالت وزارة الصحة والسكان فى بيان لها، إن الدكتورة هالة زايد، وزيرة الصحة والسكان والوفد المرافق لها سيخضعون لمجموعة من الإجراءات والفحوصات العادية، لافتا إلى أنهم سيخضعون للمتابعة لمدة 14 يوما فور وصولهم من مطار بكين.
وتابعت الوزارة: إذا كانت النتائج إيجابية سيتم العزل، وإذا كانت سلبية سيتم ممارسة الحياة بشكل طبيعي.
وكانت خضعت الدكتورة هالة زايد، وزيرة الصحة والسكان، والوفد المرافق لها، لعملية الفحص والإجراءات الوقائية فور وصولها مطار بكين.
وكانت الدكتورة هالة زايد، وزيرة الصحة والسكان أعلنت امس الأول عن توجهها إلى جمهورية الصين الشعبية، حاملة رسالة تضامن من الرئيس عبد الفتاح السيسي، إلى جمهورية الصين، في إطار عمق وترابط العلاقات بين البلدين، وتعزيز سبل التعاون لمكافحة فيروس كورونا المستجد ( كوفيد - 19).
وكان في استقبال وزيرة الصحة كل من نائب رئيس البرلمان الصيني ورئيس الصليب الأحمر بمقر البرلمان الصيني ووجه رسالة شكر للرئيس عبدالفتاح السيسي على تلك الزيارة ومساندة الشعب الصيني واللفتة الإنسانية لمصر من خلال إضاءة المعابد المصرية بالعلم الصيني.